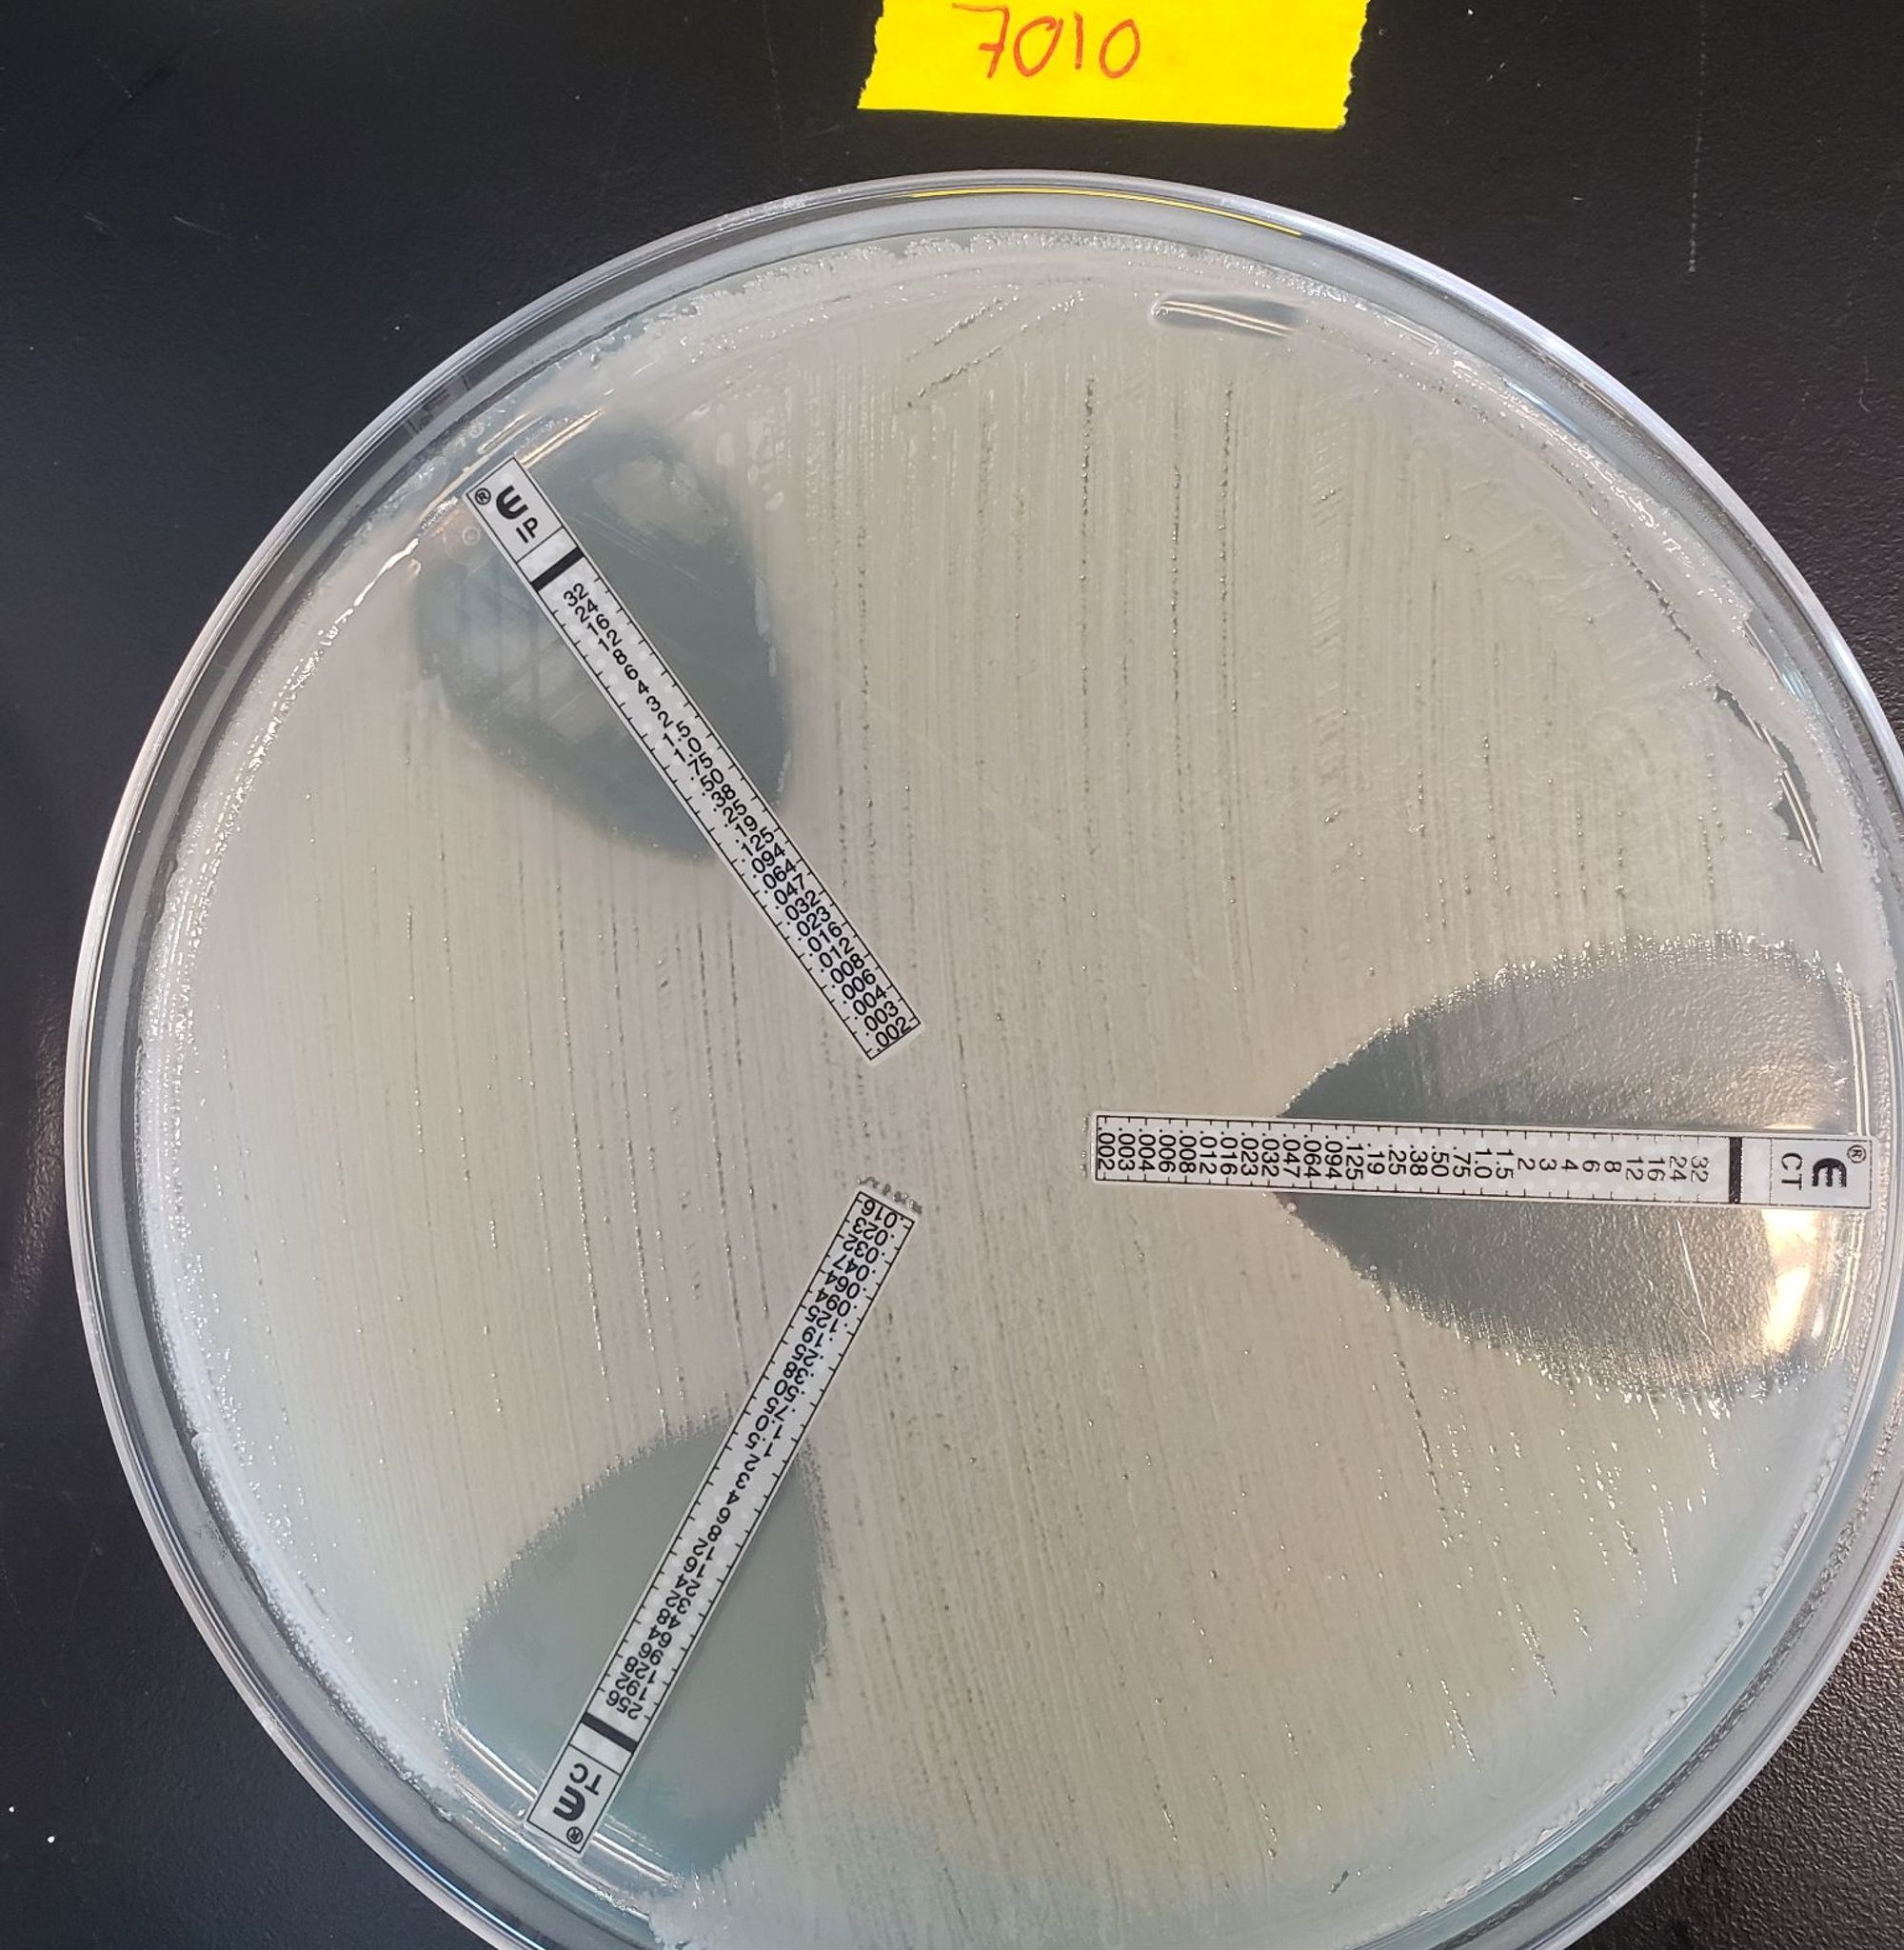
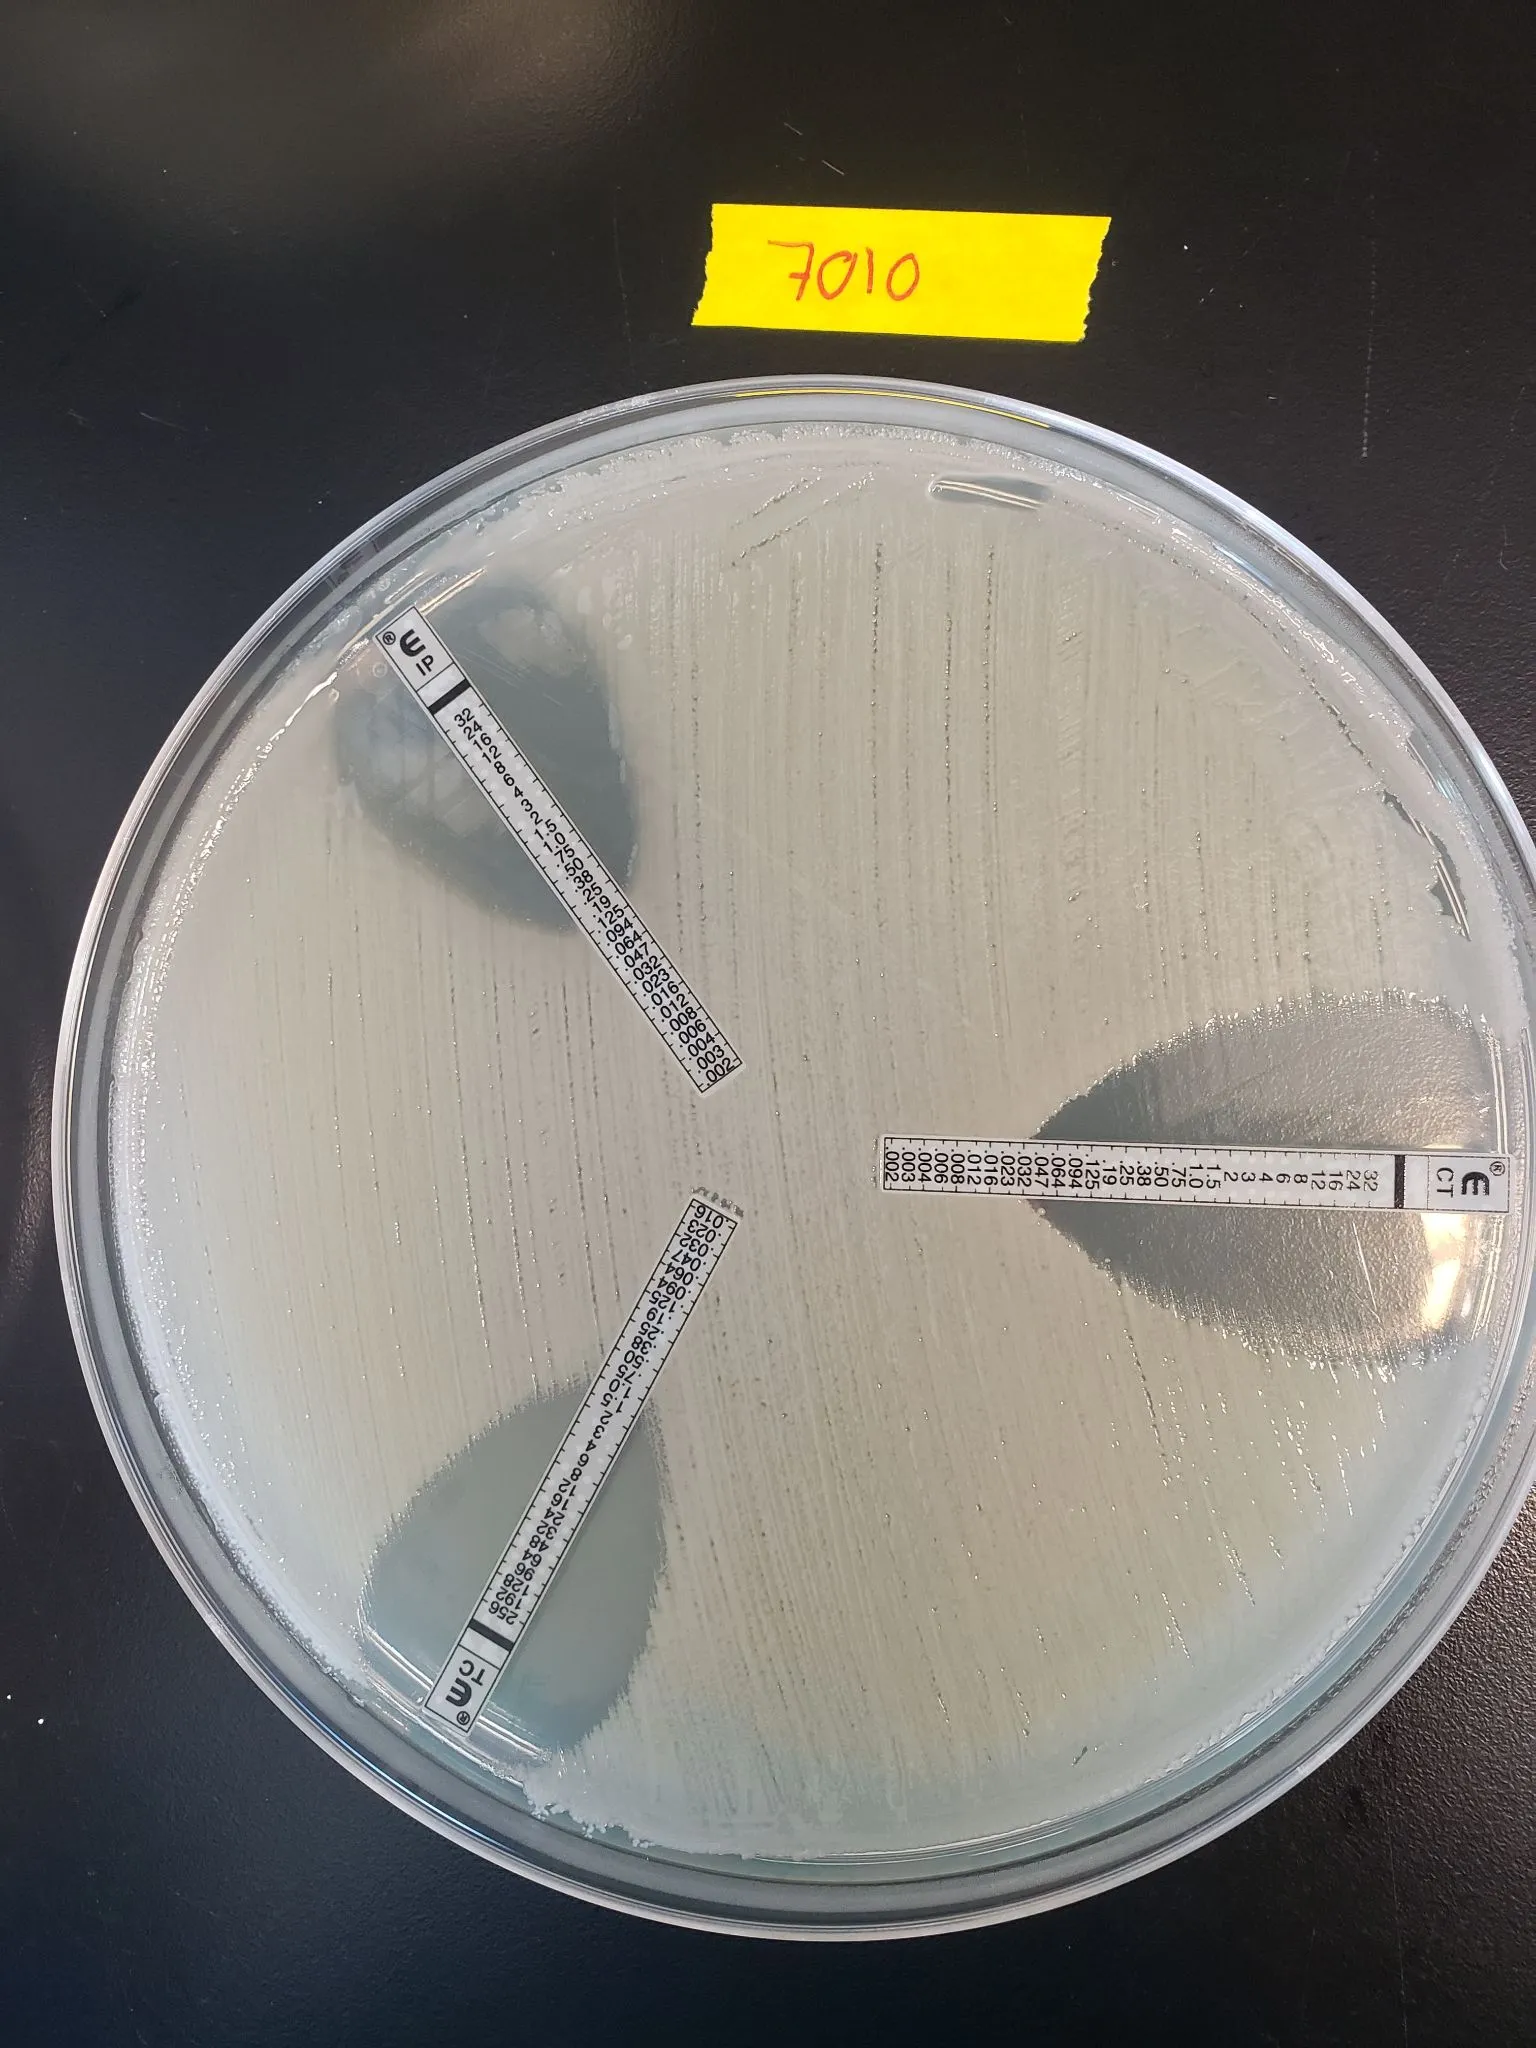

Symposium on antibiotic resistance in bioaerosols - NSERC Discovery Frontiers Project 2019
Location
Théâtre de la Cité Universitaire, Palasis-Prince, ULaval
2725 Chemin Ste-Foy Québec, Québec Canada, G1V 4G5
Dates
Registration period:
June 1, 2023 - 00:00 EDT - October 27, 2023 - 15:00 EDT
Submission period:
June 26, 2023 - 00:00 EDT - October 31, 2023 - 23:30 EDT
Contact us
If you have any questions, please contact marie-helene.pedneau@mat.ulaval.ca






